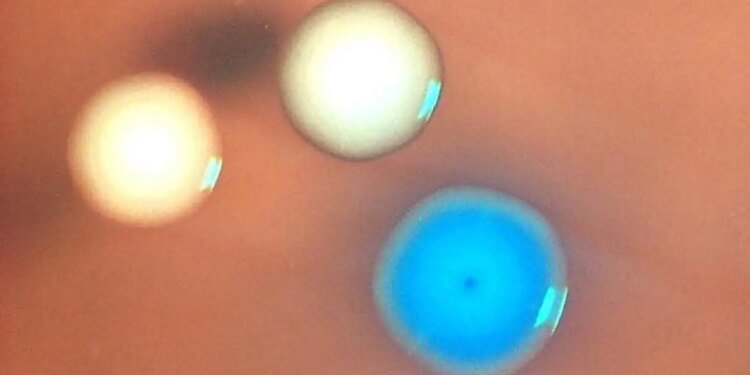

Colonies of bacterial cells under a microscope. The blue colony is expressing the synthetic genome; the white colonies are Mycoplasma capricolum cells that survived the mitomycin C treatment
Nacyra Assad-Garcia
A living, synthetic cell has been made by transplanting a complete genome into a dead bacterium, bringing it back to life. The breakthrough could help synthetic biology live up to its huge, but still distant, promise of engineering organisms to create sustainable fuels, pharmaceuticals and new materials.
Synthetic biology involves tweaking biological systems or creating new ones to introduce novel functions, such as rewriting yeast DNA so that the organisms make desirable chemicals. In an effort to make more versatile engineered microbes, in 2010 researchers synthesised a bacterial genome and then transplanted it into a living cell, creating what they called the first synthetic cell.
But there was a problem. It was very difficult to be sure whether the cell was truly being governed by the synthetic genome rather than its original genome, because bacteria frequently absorb genetic material from the environment and add it to their own genomes in a process called horizontal gene transfer.
To get around this issue, John Glass at the J. Craig Venter Institute (JCVI) in La Jolla, California, and his colleagues decided to kill the host cell first – or at least its genome.
The researchers turned to a chemical called mitomycin C, used as a chemotherapy drug to kill cancer cells by damaging their DNA, and tried it on cells of the simple bacterium Mycoplasma capricolum.
“The cell is still healthy but since it cannot reproduce any more and the genome is not functional any more, it is destined to die or it’s already dead,” says team member Zumra Seidel, also at the JCVI.
Next, they added a synthetic version of the genome of another bacterium, Mycoplasma mycoides, to the dead cells using a technique they call whole-genome transplantation.
Some of the bacteria began to grow and divide normally and genetic tests showed they carried the synthetic genome. This makes them the first living, synthetic bacterial cells constructed from non-living parts, claim the researchers, who call them “zombie cells” because they have been revived after death.
“We take a cell without a genome and it is functionally dead. But by adding a new genome, that cell is resurrected,” says Glass.
Kate Adamala at the University of Minnesota calls the work a technical breakthrough. “They’re putting a genome payload into a non-living recipient, so they’re getting no help from the host’s own repair mechanisms. They essentially booted that cell back up,” she says. “It’s amazing work.”
It also blurs the line between life and non-life, says Adamala. “The business model of any proper living cell is to metabolise and replicate. Those functionalities became the hallmark of life. The recipient [cell’s genome] in this does very little of residual metabolising and is most certainly not replicating. What is then a true hallmark of life?”
Team member Elizabeth Strychalski at the National Institute of Standards and Technology in Gaithersburg, Maryland, suggests that biology may routinely operate across a porous boundary between life and death. “I hope this prompts people to think about how life is a series of processes and if we bring an engineering mindset to that, we can look at our living system and ask which processes we really need for the end goal that we’re trying to accomplish.”
So far, the technique has only been tried on Mycoplasma, but the team sees it as proof of principle that could enable faster creation of synthetic organisms to work as mini chemicals factories, making therapeutic drugs or performing environmental remediation.
“For a long time, we have had the ability to assemble very large pieces of synthetic DNA, but we haven’t been able to deliver them to a place where they can do useful things,” says Strychalski. “It’s like having a script for a Shakespeare play, but not being able to actually perform it.”
Akos Nyerges at Harvard Medical School says the work addresses a major challenge in synthetic biology. “This technology makes genome transfer a more predictable and reliable strategy, which potentially opens up a lot of follow-up applications in other species,” he says.
Moving towards more complex organisms like yeast or E. coli may be challenging, because these organisms have a cell wall, which Mycoplasma lacks, and bigger genomes, but Glass is optimistic the technique will succeed in them, too.
“If this works for one type of organism, it is likely to work for another,” he says, and his lab is investigating ways to remove and replace cell walls. “In the right growth conditions, E. coli will make a new cell wall,” he says.
There is always the possibility of biosafety issues with synthetic biology, says Nyerges. The Mycoplasma species used in the study are pathogens in goats and cattle, but he says none of the modifications are expected to increase virulence.
Strychalski says existing laboratory best practices make sure the risk of pathogens escaping is minimal.
Topics:
- biotechnology /
- microbiology
Source link : https://www.newscientist.com/article/2520182-zombie-cells-created-by-transplanting-genomes-into-dead-bacteria/?utm_campaign=RSS%7CNSNS&utm_source=NSNS&utm_medium=RSS&utm_content=home
Author :
Publish date : 2026-03-23 10:47:00
Copyright for syndicated content belongs to the linked Source.